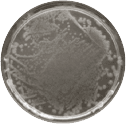
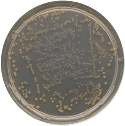
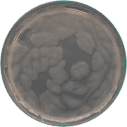

Sustainable Sterilization Technology
Cerafusion™ is chemical free, safe and a green technology.
Cerafusion™ creates Active Oxygen just as nature does and it eliminates 99.9% of viruses, bacteria, mould, allergens, odours and pollutants in the air and on surfaces.

Cerafusion™ Cartridge
Our patented technology harnesses the power of nature to create Active Oxygen to clean any indoor environment.
Cerafusion™ Cartridge
Our patented technology harnesses the power of nature to create Active Oxygen to clean indoor environment. Nature creates Active Oxygen through photosynthesis, moving water, UV rays and thunderstorms.

It is made up of O₃ and O– molecules.


Together, they form Active Oxygen, nature’s most powerful sterilizing force, eliminating up to 99% of viruses, bacteria, mould, allergens, odours and pollutants in the air and on surfaces in any indoor environment.

The 5 Ways Active Oxygen Sterilizes Your Air & Surfaces
1. Active Oxygen eliminates viruses and bacteria by:
-
- Breaking down bacterial cell walls.
- Damaging viral DNA and RNA.
2. Active Oxygen oxidizes Volatile Organic Compounds (VOCs) like formaldehyde, a cancer causing chemical.
3. Active Oxygen denatures allergens such as dust mite allergens.
4. Active Oxygen eliminates odours such as

5. Active Oxygen eliminates airborne particles such as:

Test Report on
Cerafusion™ Technology
| Bacteria/Mould Type | Without Cerafusion™ Technology | With Cerafusion™ Technology | Test Results |
|---|---|---|---|
|
Candida Albicans
|

|

|
100% Killed |
|
Pseudomonas Aeruginosa
|
|

|
99.99% Killed |
|
Escherichia Coli
|

|

|
99.99% Killed |
|
Methicillin-resistant Staphylococcus Aereus
|
|

|
100% Killed |
|
Rhizopus Species
|

|

|
No Mould Growth |
|
Bacillus Species
|
|

|
100% Killed |
Comparison of mould growth on exposed bread after 10 days in room temperature in the absence or presence of a Medklinn Air and Surface Sterilizer.
Test Procedure:
Bacteria or yeast were spread on agar plates. The plates were then incubated in two humidified incubators — one with Cerafusion™ Technology and one without.
Test Conducted by:
Associate Professor Sek C. Chow
Dr Med Sc, Registered Toxicologist (UK)
Monash University, Sunway Campus
Dr. Anne Vaughan
Lecturer, School of Science
Monash University, Sunway Campus














